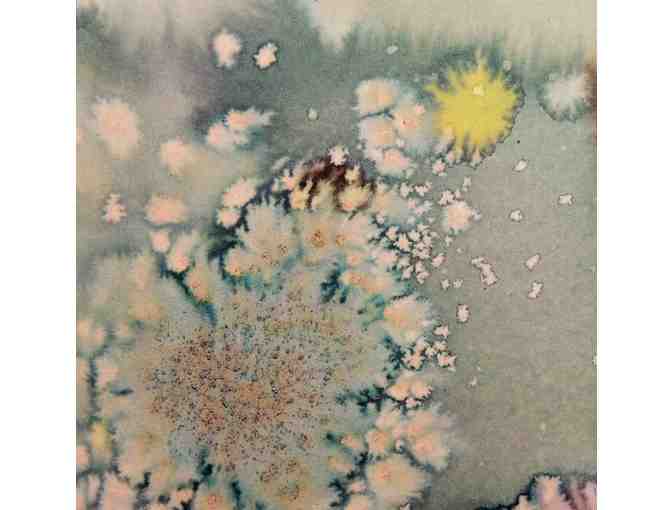

G1-5 - Camoufflage by Lucien

Item Number: 423
Time Left: CLOSED
Description
Camoufflage by Lucien
Special Instructions
Special thanks to teacher Benedicte Cambon.
Donated by
The students of G1-5 and their teachers
Item Number: 423
Time Left: CLOSED
Camoufflage by Lucien
Special thanks to teacher Benedicte Cambon.